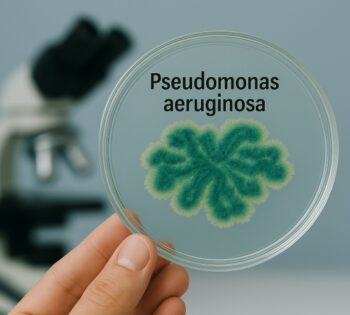
Pseudomonas aeruginosa agricultura

Una bacteria que vive entre dos mundos
Pseudomonas aeruginosa es una bacteria gram negativa, muy metabólicamente versátil y capaz de vivir en muchos ambientes (suelo, agua, superficies húmedas), pero con una particularidad clave: es también un patógeno oportunista humano. Este simple hecho cambia por completo la conversación cuando alguien propone su uso agrícola.
Puede que en más de un documento se la mencione como promotora del crecimiento vegetal, incluso como candidata a biocontrol. Sin embargo, conviene ver más allá del titular y pensar qué significa su presencia en un entorno agrícola real.
Suelos, humedad y actividad humana
Esta especie es ubicua y adaptable. Puede aparecer en baja abundancia en suelos y aguas, y es frecuente en entornos “humanizados”, es decir, aquellos impactados por actividad humana: sistemas de riego, depósitos de agua, instalaciones con cierta humedad persistente. Por eso, su detección en metagenómica o en aguas de riego no debería sorprender a nadie.
Pero también debería encender alarmas si alguien la encuentra en abundancia. La “abundancia durante todo el año” es un indicador de desequilibrio ecológico. En algunos contextos, se ha asociado a suelos contaminados con metales pesados o a malas prácticas agrícolas.
El biofilm, su mejor arma
Uno de los rasgos más llamativos de Pseudomonas aeruginosa es su capacidad de formar biofilms. En la práctica, eso se traduce en una ventaja ecológica tremenda: puede resistir desecación, desinfectantes, antibióticos y condiciones hostiles.
Esto la convierte en una superviviente nata. Puede persistir en tuberías, depósitos, sistemas de riego, instrumentos contaminados o incluso en el interior de tejidos vegetales. También la hace un problema serio en medicina, donde destaca por infecciones en personas vulnerables y por su multirresistencia en muchos contextos clínicos.
En sistemas agrícolas, esta capacidad biofilm la vuelve difícil de eliminar cuando coloniza nichos húmedos. Si la detectas en biofilm de depósitos, lo más útil suele ser tratarla como indicador de humedad crónica o higiene deficiente del sistema, no “multiplicarla”.
¿Amiga o enemiga en el campo?
Aquí llega el punto clave. En muchos textos se habla de los beneficios de las pseudomonas en agricultura. Y es cierto: muchas especies del género tienen funciones como solubilización de fósforo, producción de sideróforos, síntesis de hormonas tipo iaa, y competencia en la rizosfera.
En los apuntes que analizamos se menciona incluso su papel en la biorremediación: ayudar a descontaminar suelos, quelar metales, acidificar ambientes y competir con patógenos.
Pero hay que ser claros: la clave no es la “especie”, sino la “cepa”. En usos agrícolas regulados se trabaja con cepas concretas evaluadas (por ejemplo, efsa revisa y se aprueban cepas específicas de pseudomonas para usos fitosanitarios), no “cualquier pseudomonas”.
Lo que sí puede aportar (y lo que no)
Pseudomonas aeruginosa ha sido estudiada como fuente de biosurfactantes. Se menciona en diversos estudios que sus rhamnolípidos actúan como surfactantes naturales, útiles en ciertos contextos de descontaminación de suelos o sistemas acuáticos.
Sin embargo, en ninguno de los textos analizados se proporciona información específica sobre dosis, formulaciones agrícolas viables o registros oficiales para su aplicación en campo.
Por tanto, aunque desde la biotecnología pueda aprovecharse para la producción de compuestos útiles, eso no significa que sea recomendable como inoculante agrícola.
Riesgos reales y precauciones necesarias
Pseudomonas aeruginosa se maneja típicamente como microorganismo bsl-2 o del grupo de riesgo 2. No es un “microbio inocuo” para manipular sin medidas. Por su vinculación con infecciones en humanos, su uso en agricultura plantea dudas importantes de bioseguridad y reputación.
En mi experiencia, el coste/riesgo de bioseguridad y reputación supera el beneficio: es un organismo asociado a salud humana y se clasifica para manejo bsl-2. Si aparece en análisis (metagenómica, agua de riego, biofilm de depósitos), lo más útil suele ser tratarlo como indicador de nichos húmedos/biofilm y revisar higiene de sistemas, no “multiplicarlo”.
La pseudomonas “mala” y la pseudomonas “buena”
En el enfoque técnico que revisamos, se enfatiza que “cada bacteria en su lugar”. El problema no es que existan pseudomonas, sino dónde y cómo aparecen.
En un ejemplo agronómico narrado en los apuntes, se describe un caso en olivo donde un subsoleo profundo habría “extraído pseudomonas de la profundidad” y las habría puesto en superficie. Con suelo desnudo, aire dispersando, etc., y la bacteria termina asociándose a cancros (“tumor negro”) y muerte de ramas/tronco.
En esa situación, entró al sistema vascular del árbol, desarrollando biofilms dentro del tejido. Es decir, lo que normalmente sería una bacteria del subsuelo, se volvió un problema por una práctica de manejo que desestabilizó el ecosistema microbiano.
Qué debe saber un agricultor
Desde una perspectiva operativa, las recomendaciones más claras serían:
Si tu interés es pgpr o biocontrol, enfócate en otras especies o cepas de pseudomonas con mejor perfil de seguridad y uso agrícola habitual. Y, si aplica, usa formulados o cepas registradas, no pseudomonas aeruginosa.
Si te sale en agua o depósito, piensa en biofilm y en puntos críticos: filtros, depósitos, tuberías, zonas con estancamiento, y procedimientos de limpieza compatibles con tu sistema.
Evita prácticas que invierten estratos (como subsoleo profundo más rotavator) si estás en suelos con historial de cancros o desequilibrio microbiano.
Asegura higiene en poda: al cortar ramas enfermas, desinfecta el instrumental entre árbol y árbol para no reinfectar.
Establece cobertura vegetal, elimina rotavator si no es indispensable, y considera el uso de cicatrizantes naturales tras cortes, como cera más trementina más resina.
Si necesitas competir contra pseudomonas en el suelo, puedes inocular bacterias firmicutes obtenidas de aloe vera o de opuntia, tal como sugieren los documentos.
Lo que necesitas saber si te aparece en finca
Cuando la pseudomonas no es bienvenida
Aunque la pseudomonas aeruginosa no sea una plaga ni un hongo patógeno como los que estamos acostumbrados a combatir, su presencia en sistemas agrícolas puede ser una señal de alerta. No porque “ataque” directamente al cultivo, sino por lo que implica sobre el estado del sistema.
En más de una finca que he visitado, su aparición coincidió con biofilms visibles en tuberías, depósitos con olor extraño o baja eficacia de los tratamientos de fertirriego. El agricultor no sabía que ahí dentro había una comunidad bacteriana organizada, persistente, y difícil de eliminar con los métodos habituales.
Caso 1: biofilm en sistemas de riego
En un invernadero de tomate, el productor detectaba obstrucciones recurrentes en goteros. Al abrir la línea, encontró una capa viscosa de color marrón-verdoso. El análisis reveló pseudomonas aeruginosa como una de las especies dominantes.
Lo interesante no fue solo encontrarla, sino entender por qué estaba ahí: las líneas se vaciaban mal, el depósito tenía acumulaciones en la base, y no había protocolo de choque para limpieza. Esta bacteria no había sido introducida “a propósito”, sino que había encontrado su hábitat ideal.
la solución no fue eliminarla con un biocida agresivo, sino rediseñar los protocolos: lavado de líneas, purgas programadas, uso de productos limpiadores compatibles y revisión periódica. Desde entonces, el biofilm dejó de aparecer.
Caso 2: pseudomonas en análisis metagenómico
Un productor de aguacate aplicó compost líquido rico en microorganismos. Tiempo después, en un análisis metagenómico de rizosfera, apareció pseudomonas aeruginosa en baja proporción. No había síntomas en planta ni problemas visibles, pero la duda era clara: ¿es preocupante?
la respuesta fue contextual. la cepa no estaba activa ni formando colonias dominantes, y posiblemente provenía del propio compost. no había indicios de desequilibrio. se decidió no actuar, pero sí ajustar el proceso de compostaje para mejorar el control de temperatura y asegurar que no sobrevivieran organismos de riesgo.
este caso muestra que no toda detección implica acción inmediata, pero sí reflexión. conocer el origen y evaluar el comportamiento de la bacteria es clave para decidir.
Caso 3: pseudomonas tras lluvias intensas
En una finca de olivo, tras un año con lluvias muy superiores al promedio, se registraron cancros en troncos y muerte de ramas. El análisis microbiológico detectó alta abundancia de pseudomonas aeruginosa en los tejidos afectados.
Al revisar las prácticas del año, se descubrió que se había hecho un subsoleo profundo antes de las lluvias, exponiendo bacterias del subsuelo que, junto con la humedad constante, generaron condiciones para colonizar zonas vulnerables del árbol.
Este es uno de los mejores ejemplos de cómo una práctica mecánica, sumada a un año climático atípico, puede desencadenar un problema que inicialmente no estaba en el radar del agricultor. En este caso, la pseudomonas no era el enemigo original, pero aprovechó la situación creada.
Qué hacer si te sale en análisis
- No entres en pánico. Si aparece en un análisis, el primer paso es entender en qué contexto se detectó: ¿agua de riego?, ¿biofilm?, ¿suelo?, ¿tejido vegetal?
- Evalúa la cantidad. Una detección puntual y en baja abundancia no significa riesgo. Su presencia aislada puede deberse a múltiples factores.
- Investiga su origen. Puede venir del agua, de un compost, de un bioinsumo mal fermentado o incluso de herramientas mal desinfectadas.
- Revisa tus puntos críticos. Si hay zonas húmedas, estancamientos, materiales orgánicos en descomposición o falta de higiene, empieza por ahí.
- No la uses como inoculante. Aunque veas artículos que mencionan sus efectos “beneficiosos”, no es una especie recomendada en finca. Hay alternativas mucho más seguras.
¿Sirve para algo? sí, pero no en tu finca
Hay una confusión habitual entre lo que una bacteria “puede hacer” y lo que es recomendable usar en la práctica. Pseudomonas aeruginosa puede producir biosurfactantes útiles para procesos industriales o de biorremediación. Pero eso no la convierte en una aliada agrícola directa.
En biotecnología se usa en condiciones controladas, en laboratorios con normas de bioseguridad, para obtener compuestos de interés. Pero eso no justifica soltarla en campo abierto o en un invernadero.
Alternativas seguras
Si buscas funciones como solubilización de fósforo, producción de sideróforos o biocontrol de hongos, puedes encontrar todo eso en cepas registradas y seguras de otras especies de pseudomonas.
Por ejemplo:
- pseudomonas fluorescens: ampliamente usada como biocontrol.
- pseudomonas putida: excelente PGPR con seguridad comprobada.
- bacillus subtilis: otra opción versátil con propiedades antifúngicas.
- azospirillum spp.: para fijación biológica de nitrógeno y estímulo radicular.
Trabajar con microorganismos debe ser siempre una decisión informada, basada en cepas evaluadas, con trazabilidad y respaldo técnico.
El riesgo reputacional
Más allá de la biología, hay un punto práctico que muchos agricultores subestiman: el riesgo reputacional. ¿Cómo afecta a tu finca si usas una bacteria asociada a infecciones humanas? ¿Qué pasa si un inspector encuentra esa especie en tu sistema?
Usar pseudomonas aeruginosa como inoculante puede generar más dudas que beneficios. Aunque tú tengas claro que no es una cepa clínica, no todos lo entenderán igual. Y si estás en producción certificada o exportas, eso puede ser un problema real.
Conclusión: no todas las pseudomonas son iguales
Hablar de pseudomonas aeruginosa agricultura es hablar de una especie compleja, con una cara útil desde la biotecnología pero una carga de riesgo importante en el manejo práctico.
En resumen, yo no la usaría como “inoculante” en finca. La clave está en evaluar cepas concretas, entender su origen ecológico y evitar generalizaciones. Hay muchas pseudomonas especies beneficiosas que sí tienen historial positivo en campo, pero pseudomonas aeruginosa no está entre ellas.
Si quieres mejorar tus resultados o hacer una transición hacia una agricultura más sostenible, podemos ayudarte.